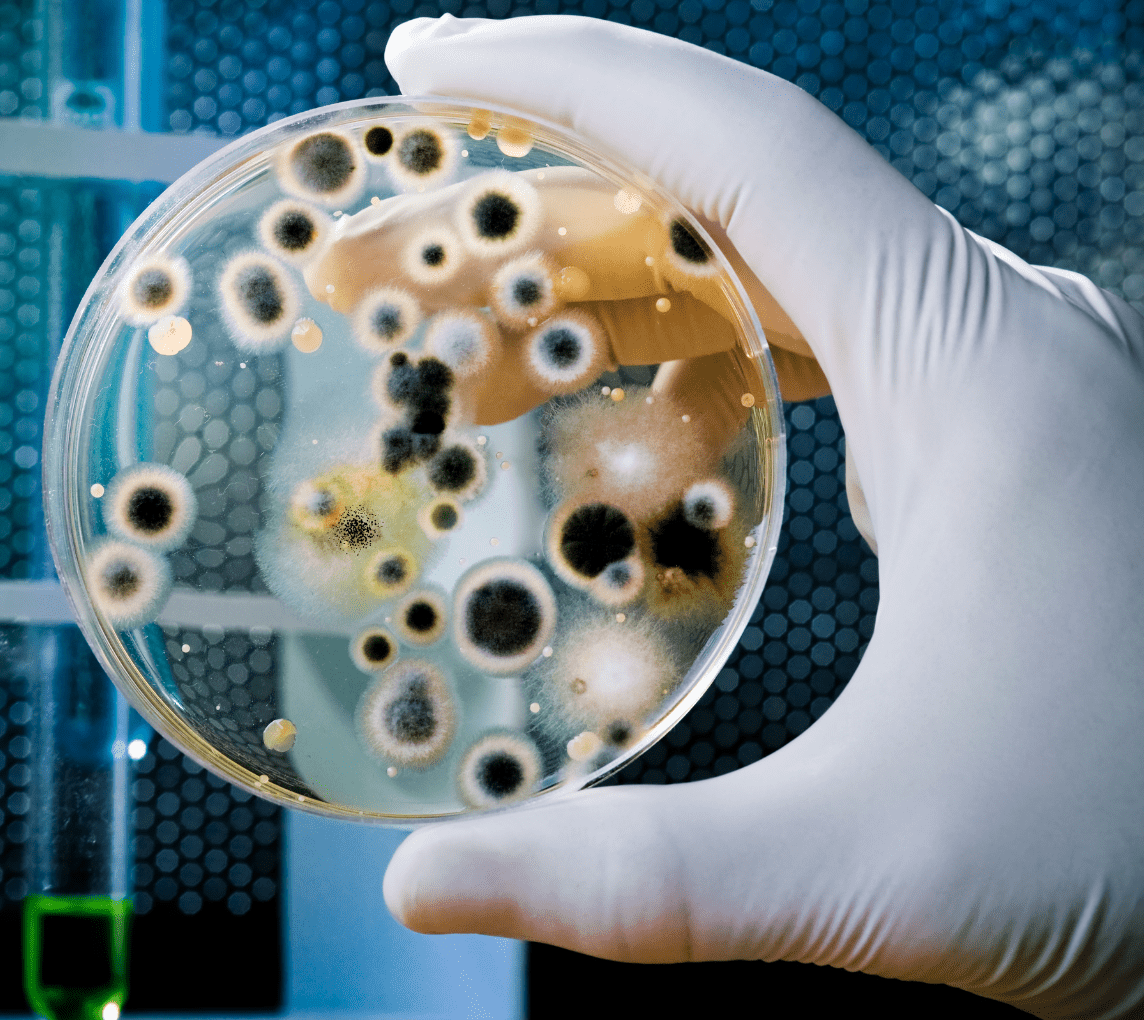
Environmental Solutions

Commercial Indoor Air Quality Testing: Why It Matters and How It Protects Your Workplace
Indoor air quality (IAQ) is one of the most overlooked factors impacting employee health, productivity, and building performance. In commercial...
At NoVA, we provide expert environmental solutions to help clients manage risk, ensure compliance, and protect health across mold, lead, asbestos, air quality, and industrial hygiene.
NoVA Environmental Solutions provides comprehensive environmental consulting and testing services for commercial, industrial, and residential clients. Our certified professionals deliver reliable, regulatory-compliant solutions to protect people, property, and the environment.
Environmental Solutions You Can Trust Delivering Environmental Consultingwith precision and purpose.

NES offers a comprehensive suite of environmental consulting and testing services, including asbestos surveys, lead testing, mold inspections, indoor air quality assessments, hazardous building materials surveys, water testing, and industrial hygiene services. We serve clients across construction, real estate, manufacturing, healthcare, and property management sectors.
Mold can affect air quality, structure, and health. Our certified team provides full mold inspections, limited inspections, and PRV checks. We find visible and hidden mold, assess moisture issues, and deliver clear documentation for proper remediation.
Water testing protects health, safety, and regulatory compliance. Our certified team conducts lead, bacterial, and chemical contaminant analysis for residential, commercial, and industrial sites. We identify risks, verify treatment results, and deliver clear reports to guide safe water management.
Indoor air quality affects comfort, safety, and overall performance. Our assessments detect mold spores, VOCs, allergens, carbon monoxide, and other pollutants. We identify risks, deliver clear findings, and support effective strategies for maintaining healthy indoor environments.
Asbestos can affect safety, compliance, and project timelines. Our certified team provides pre-renovation and demolition inspections, project monitoring, and final clearance. We identify risks, guide abatement, and deliver documentation to protect property.
Legionella management protects building occupants and ensures compliance. Our team provides testing, risk assessments, management plans, and verification sampling. We identify hazards, confirm disinfection success, and deliver clear guidance to maintain safe water systems.
Environmental assessments help property owners make decisions. Phase I ESAs identify potential risks through property history, while Phase II ESAs provide detailed insights for effective remediation. We guide compliance, protecting your valuable investment and assets.
Lead can affect safety, compliance, and overall property conditions. Our certified team conducts XRF testing, dust sampling, and clearance inspections. We identify hazards, assess exposure risks, and provide clear reports that guide safe and effective remediation.
Workplace safety protects employees and ensures regulatory compliance. Our team conducts air and noise monitoring, hazard identification, and exposure assessments. We evaluate risks, implement controls, and provide clear guidance to maintain a safe working environment.
Property owners, contractors, and managers reduce project risk and plan safely. We thoroughly assess asbestos, lead, PCBs, and other universal wastes, providing critical information. Clear documentation and expert guidance support safe handling, abatement, and proper disposal.

Paul and his team are fabulous, top-notch experts. Paul very generously spoke with me prior to the inspection to answer all of my questions and concerns. From his answers, I could tell his expertise was a cut above the other inpectors I spoke with, and that he really cared about doing a great job and protecting his customers' health. He wasn't salesy, quite the opposite, he genuinely wanted to make sure I had the info I needed to portect my health. On inspection day, they were here for hours, and tested surface samples, air spore levels, moisture inside walls, VOCs, humidity, and compared levels to outdoor spore counts so he could isolate indoor vs. outdoor exposure. He took the samples to the lab himself, the results came back fast, and he wrote an extremely helpful and detailed report, including a suggested remediation plan that the remediation company we hired utilized. Then, after remediation, his team tested again to make sure that all the mold was removed. I appreciated having our inspection done by a different company than the remediation company, to remove any concern for conflict of interest. Paul also referred us to a fantastic mold remediation company, and to other experts we needed to resolve our situation. If you are in their geographic area of service, I would 100% recommend you choose them.

I write to sing the praises of NoVA Environmental Solutions. I had the good fortune to consult with Paul Burger and found him to be knowledgeable and VERY patient in explaining things and answering my endless questions. He cared more about sharing knowledge than making a sale - you do not often find business that are ethical and caring in this day and age. And no, I don't know anyone personally at this company. This is an unsolicited rave review!!!!

I contacted NoVA Environmental Solutions because I needed to have an old abandoned farm house near New Market tested for asbestos before the county would issue a demolition permit. Paul spoke with me on the phone to explain how the process worked, and was able to schedule an appointment at the property the following week. He arrived on time to the appointment, and answered the questions I had during and after his inspection and taking of samples to be tested. The lab results were back within 3 business days, and NES' accompanying, detailed report met the county requirements for the permit. NES was professional and courteous from start to finish, and the fees were quite reasonable. One other factor for me in choosing them was that NES does not do asbestos abatement, or post-abatement testing; thus, even if the samples had tested positive for asbestos, NES stood no possibility of gaining further work from me. I would definitely recommend this company without hesitation to anyone seeking an honest and professional asbestos testing service.

Outstanding service! I am the property Manager for a 102 unit building and I've been a client for 3 years. Nova, headed by Paul Burger has been lead and point for 2 of my major floods requiring testing and analysis, and invaluable. Paul is an highly professional, trusted Industrial Hygienist.

As a Property Manger, I have used NoVA Environmental for testing of asbestos, mold and microbial growth and have been very satisfied with their fast response, testing and reports provided. I would highly recommend their services.
We’re proud to partner with professionals who value precision, integrity, and responsive service. From contractors to property managers, our clients trust NES to deliver reliable environmental solutions that protect people and projects.
We believe that environmental safety and regulatory excellence are essential to a thriving business ecosystem. That’s why our impact extends beyond individual projects—we actively support the broader business community through engagement with local chambers of commerce, professional organizations, and industry networks. NoVA Environmental Solutions fosters strategic partnerships that promote leadership, collaboration, and sustainable growth. By sharing knowledge, participating in initiatives, and advocating for responsible practices, we help strengthen the foundations of the industries we serve.
Expert environmental consulting and responsive service that helps clients manage risk and ensure regulatory compliance.
Fostering a collaborative culture that supports professional growth and celebrates achievement.
Upholding high standards through continuous improvement and reliable environmental testing.
Operating with honesty, respect, and ethical responsibility in every aspect of our environmental services.
Strengthening the business community through strategic partnerships, professional collaboration, and initiatives that promote leadership and growth.
Don’t wait for small issues to become big problems. Whether you're concerned about mold, lead, asbestos, industrial hygiene, Legionella, water, or air quality, NoVA Environmental Solutions is here to help. Reach out today to schedule an inspection with our certified experts.
Indoor air quality (IAQ) is one of the most overlooked factors impacting employee health, productivity, and building performance. In commercial...
When it comes to protecting your property and indoor air quality, mold is not something to overlook. However, many property...
In commercial real estate (CRE) transactions, uncertainty can derail timelines, inflate costs, and introduce long-term liability. That’s where a phase 1...